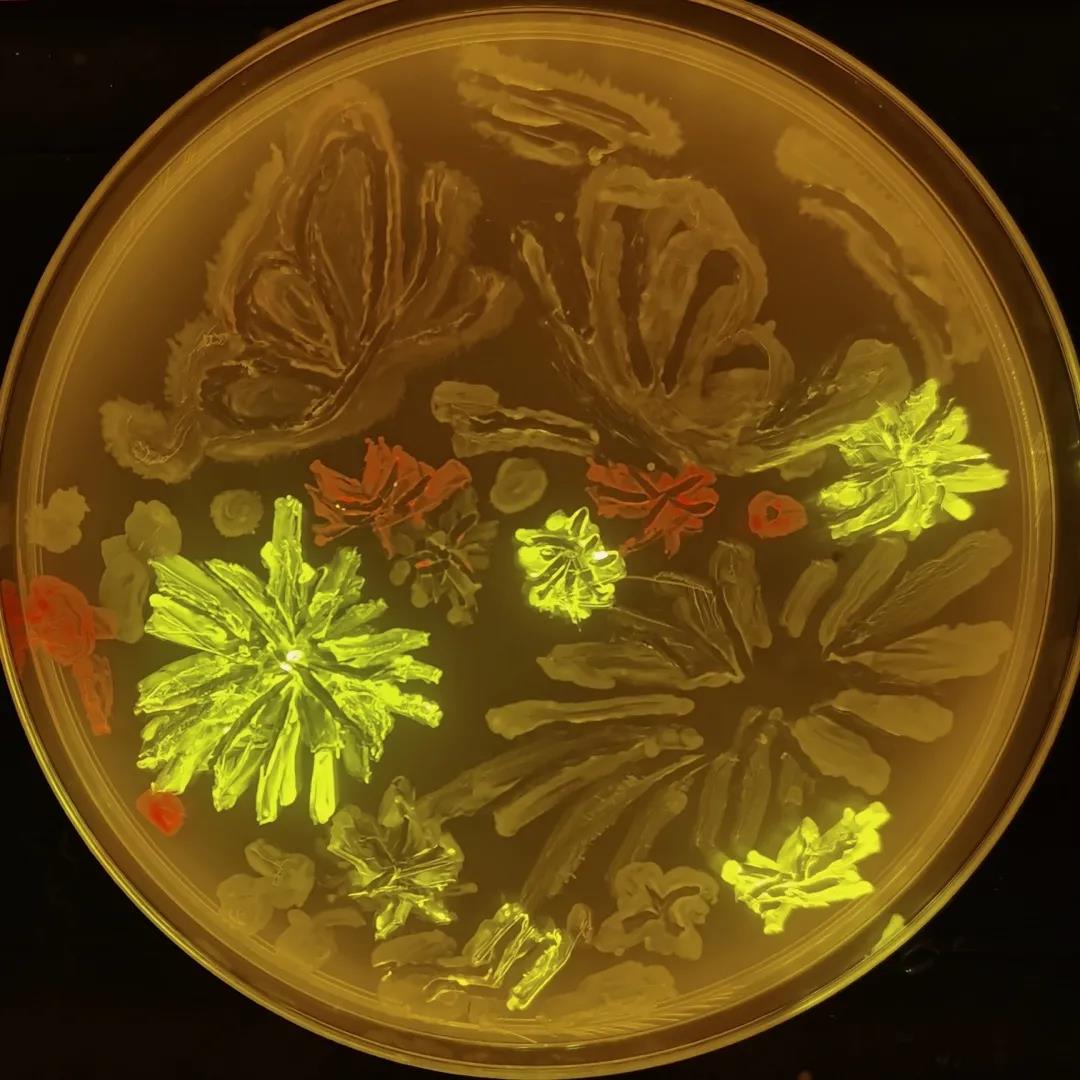
培养皿画作1

中国教育智库:盘点2020年十大教
2020年底,由由中国教育报和中国教

生物类专业怎么样?先来看几条评论



网上对于生物类专业的评论多是如此,但生物类专业真的如此不堪?
前两天看了一场演讲,是关于生物技术的应用及创业,演讲者李腾,作为清华大学生物专业的本科、硕士研究生,也提到生物专业的出口窄的问题。摆在他面前的,也是师兄前辈毕业后悲惨生活的案例。

但不会被舆论影响李腾,依靠微生物的学识和技术,创办了一家微生物公司,方向是可降解物品,五年后的今天,终取得备受认可的成绩。图中背景是李腾所在公司2022年投产的生产基地。
狼行千里吃肉,狗行千里吃shi
如果不能把自己喜欢的事变成终身奋斗的事业,只能把终身的事业变成自己的喜欢的事。一个是改变外部世界,一个是改变自己内心。哪个更有勇气,哪个更符合人类发展的需求,不言而喻。
抛开功名利益,生物类专业有让人喜欢的魅力吗?来看看天津大学化工学院19级学生的微生物培养皿的的创作:

这些将科学之美与艺术之美相结合的作品,需要同学们掌握微生物分离、培养等无菌操作技术,同时还要认知细菌、霉菌、放线菌、酵母菌等十余种微生物的典型形态和生长特性。最重要的,这些作品都是活的,充满生机的!
按照惯例,想要报考大学生物类专业,无论是生物工程,生物信息等专业,高中选科时要切记:
高考“3+3”模式也好,“3+1+2”模式也好,文理分综也好,统一最佳选科组合:物理+化学+生物。
学生物的流行这句话“21世纪是属于生物的!”既然喜欢,就全力以赴。把曾经的豪情壮志当成日后自嘲的笑料,那不是认清现实的成熟,而是怯懦逃避的耻辱。